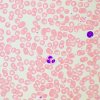
83479 magus bio 260t img 03

Biologický mikroskop MAGUS Bio 260T
Expresní doručení
Velký výběr
Osobní přístup
Výhodné ceny
Mikroskop MAGUS Bio 260T je denní mikroskop, který lze použít pro laboratorní a vědecký výzkum nebo pro vzdělávací účely. Mikroskop pracuje s tenkými průhlednými a průsvitnými preparáty metodou světlého pole. Na přístroj však lze nainstalovat další součásti, které rozšíří jeho možnosti o použití metod tmavého pole, fázového kontrastu, polarizovaného a fluorescenčního světla.
Model je vybaven kódovaným revolverovým nosičem objektivů, do kterého lze umístit až pět objektivů. „Smart“ (inteligentní) osvětlení se automaticky přepíná s otočením revolverového nosiče objektivů a přizpůsobuje se parametrům každého objektivu. Díky této funkci není třeba ztrácet čas nastavováním světla, což je důležité zejména ve vzdělávacím procesu nebo když potřebujete často měnit zvětšení.
Mikroskop má trinokulární hlavici, která používá optický systém s korekcí na nekonečno. Výška zornice je nastavitelná. Její poloha se nastavuje otáčením tubusů až o 360°. V trinokulárním tubusu je instalován digitální fotoaparát. Světlo se rozděluje do fotoaparátu a okulárů v poměru 50/50. Sada mikroskopu obsahuje základní okuláry 10x/22 mm s mechanismem dioptrické korekce. Na tubusech se žádné nastavení neprovádí. Uživatelé, kteří nosí brýle, mohou využít přiložené gumové očnice, které chrání sklo před odřením a poškrábáním.
Revolverový nosič objektivů pro 5 objektivů je vybaven systémem automatického ovládání osvětlení. Při změně zvětšení uživatel pozoruje silné kolísání úrovně intenzity světla v okuláru: objektivy s různým zvětšením přenášejí světlo různým způsobem. Inteligentní osvětlení umožňuje jednorázově nastavit úroveň intenzity světla pro určitý objektiv, a když pak otočíte revolverovým nosičem objektivů, světlo se automaticky přepne. Sada mikroskopu obsahuje 4 objektivy; do pátého slotu může uživatel umístit objektiv podle potřeby. Parfokální vzdálenost je 60 mm. Slot nad revolverovým nosičem objektivů se používá k montáži analyzátoru; pokud není analyzátor nainstalován, je slot uzavřen zátkou.
Pracovní stolek pro umístění preparátu je konstruován s řemenovým pohonem: preparát se pohybuje lehce a plynule. Není zde žádný polohovací stojan v ose X, a tak je práce s mikroskopem ergonomičtější a pohodlnější. Držák preparátu je upevněn dvěma šrouby a v případě potřeby jej lze vyjmout. Dalším praktickým detailem je dlouhá rukojeť pro ovládání pracovního stolku. Uživatel může mikroskop používat s rukama opřenýma o stůl, aniž by si namáhal paže a tělo.
Kondenzor lze nastavit do požadované polohy jak vertikálně, tak vzhledem k optické ose (uchycen na rybinovém držáku). Irisová (aperturní) clona se nastavuje pomocí prstence: je opatřena indikační značkou a na těle kondenzoru jsou zobrazeny indikátory zvětšení objektivu. Pro kontrastní obraz je značka nastavena podle nainstalovaného pracovního objektivu. Kondenzor může být doplněn posuvníky tmavého pole nebo fázového kontrastu: je pro ně určen speciální slot.
Mikroskop se zaostřuje pomocí koaxiálně umístěných knoflíků pro hrubé a jemné ostření. Hrubé ostření se provádí pomocí knoflíku na levé straně. Knoflíky pro jemné ostření jsou na obou stranách stojanu a pravý z nich má speciální, pohodlné drážky pro vaše prsty. Další pohodlí při práci poskytuje kroužek pro nastavení optické dráhy mikroskopu, který umožňuje nastavit tuhost dráhy hrubého ostření způsobem, který vám bude vyhovovat. Všechny knoflíky a kroužek jsou umístěny ve spodní části stojanu: uživatel má při jejich ovládání ruce pohodlně opřeny o stůl.
Osvětlení v mikroskopu zajišťuje 3 W LED dioda umístěná v osvětlovací soustavě pro pozorování v procházejícím světle. Teplota osvětlení zůstává stabilní i při změnách jasu. Volitelné výzkumné metody tohoto mikroskopu zahrnují použití Köhlerova osvětlení. Díky němu je celé pole preparátu osvětleno rovnoměrně a artefakty, jako je prach nebo obraz světelného zdroje, nejsou přes okulár nebo digitální fotoaparát viditelné.
Zvolené provozní parametry můžete zobrazit a upravit pomocí vestavěného displeje. Nachází se na základně mikroskopu. Na displeji se zobrazuje zvětšení pracovního objektivu, parametry osvětlení, provozní režim a doba automatického vypnutí.
Funkčnost přístroje mohou rozšířit další prvky. Sada okulárů může zvýšit spektrum zvětšení. Pro další metody práce s preparáty, které nelze pozorovat metodou světlého pole, je nutné doplnit mikroskop zařízením pro fázový kontrast, posuvníkem pro tmavé pole nebo polarizačním zařízením. Digitální fotoaparát může pomoci zachytit výsledky studie na fotografii nebo videu nebo zobrazit obrázek na obrazovce. Objekty můžete měřit pomocí kalibračního sklíčka ve spojení s okulárem se stupnicí nebo digitálním fotoaparátem.
Klíčové vlastnosti:
- Mikroskop je určen pro vzdělávání a laboratorní a vědecký výzkum
- Pracuje s průhlednými a průsvitnými preparáty; osvětlovací soustava pro pozorování v procházejícím světle je založena na tříwattové LED diodě
- Osvětlení lze nastavit použitím Köhlerovy metody
- Kódovaný revolverový nosič objektivů nastavuje jas světla pro každý objektiv
- Současně lze nainstalovat pět objektivů
- Trinokulární hlava podporuje instalaci digitálního fotoaparátu; dělení paprsku 50/50
- Oční reliéf se nastavuje otáčením tubusů
- Mikroskop je vybaven vestavěným displejem, na kterém se zobrazují provozní parametry
- Další příslušenství vám umožní provádět studie v odraženém světle, v tmavém poli, metodou fázového kontrastu, fluorescence a polarizace
Obsah sady:
- Stojan s vestavěným napájecím zdrojem, zdrojem procházejícího světla, zaostřovacím mechanismem, pracovním stolkem, držákem kondenzoru a revolverovým nosičem objektivů
- Abbeův kondenzor
- Trinokulární hlava
- Rovinný achromatický objektiv s korekcí na nekonečno: 4x/0,10, parfokální výška 60 mm
- Rovinný achromatický objektiv s korekcí na nekonečno: 10x/0,25, parfokální výška 60 mm
- Rovinný achromatický objektiv s korekcí na nekonečno: 40x/0,65, parfokální výška 60 mm
- Rovinný achromatický objektiv s korekcí na nekonečno: 100x/0,25 olej (odpružený), parfokální výška 60 mm
- Okulár 10x/22 mm s dlouhým očním reliéfem a dioptrickou korekcí (2 ks)
- Očnice okuláru (2 ks)
- Adaptér pro fotoaparát s držákem C-mount
- Nádobka s imerzním olejem
- Síťový napájecí kabel
- Protiprachová krytka
- Uživatelská příručka a záruční list
K dispozici na přání:
- 10x/22 mm okulár se stupnicí
- 10x/22 mm okulár s optickou mřížkou
- 10x/22 mm okulár s nitkovým křížem
- 12,5x/17,5 mm okulár (2 ks)
- 15x/16 mm okulár (2 ks)
- 20x/12 mm okulár (2 ks)
- Rovinný achromatický objektiv s korekcí na nekonečno: 20x/0,40, parfokální výška 60 mm
- Zařízení pro fázový kontrast: sada fázových posuvníků, pomocný centrovací dalekohled pro fázový kontrast, sada fázových objektivů
- Posuvník tmavého pole
- Osvětlovací soustava pro pozorování v odraženém světle
- Polarizační zařízení
- Digitální fotoaparát
- Kalibrační sklíčko
- Monitor
| Značka | MAGUS |
| Záruka | 5 let |
| EAN | 5905555019451 |
| Velikost balení (DxŠxV) | 47x32x67 cm |
| Přepravní hmotnost | 12.2 kg |
| Typ | biologický, světlo / optické |
| Typ hlavy mikroskopu | trinokulární |
| Hlava | Gemelova hlava (Seidentopf, otočná o 360°), s 50/50 distribucí světelného toku |
| Úhel sklonu hlavy | 30° |
| Zvětšení, x | 40 — 1000 |
| Rozsah zvětšení | od 800x do 1280x |
| Zvětšení, x (volitelné) | 40–1250/1500/2000 |
| Průměr tubusu okuláru v mm | 30 |
| Okuláry | 10x/22, dlouhý oční reliéf (*volitelně: 10x/22 se stupnicí, 10x/22 s optickou mřížkou, 10x/22 s nitkovým křížem, 12,5x/16, 15x/16, 20x/12, 30x/8) |
| Objektivy | rovinné achromatické: 4x/0,10; 10x/0,25; 40x/0,65; 100x/1,25 olej (*volitelně: 2x/0,06; 20x/0,40; 60x/0,80; 100x/1,10 voda; Plan Apo 60x/1,42 olej, sada rovinných poloapochromatických fluorescenčních objektivů 4x/10x/20x/40x/100x olej); parfokální výška 60 mm |
| Revolverový nosič | 5 objektivy, kódovaný |
| Pracovní vzdálenost, mm | 30 (4x); 10,2 (10x); 1,5 (40x); 0,2 (100xs) |
| Mezipupilární vzdálenost (IPD), mm | 47 — 75 |
| Stolek, mm | 230x150 |
| Zdvih stolku pomocí zaostřovacího mechanismu, mm | 78/54 |
| Pracovní stolek, mm | dvouosý mechanický stolek, bez polohovacího stojanu |
| Dioptrická korekce okuláru, dioptrií | ±5D na každém okuláru |
| Dioptrická korekce okuláru | yes |
| Kondenzor | středově a výškově nastavitelný Abbeův kondenzor NA 1,25 s nastavitelnou aperturní clonou a slotem se zástrčkou pro posuvník tmavého pole a posuvník fázového kontrastu; rybinový držák |
| Clona | nastavitelná aperturní clona, nastavitelný kondenzor s irisovou clonou |
| Zaostření | koaxiální, hrubé ostření (30 mm, 37,7 mm/kruh, s mechanismem pro nastavení tuhosti) a jemné ostření (0,002 mm, 0,2 mm/kruh) |
| S osvětlením | LED |
| Regulace jasu | yes |
| Napájení | 100–240 V, 50/60 Hz, AC síť |
| Typ světelného zdroje | 3 W LED |
| Rozsah provozní teploty, °C | 0 — 70 |
| Další vlastnosti | automatické nastavení jasu při přepínání objektivů, režim spánku, zobrazení stavu na LCD obrazovce, úsporný režim |
| Možnost připojení dalších zařízení | epifluorescenční nástavec, polarizační zařízení (polarizátor a analyzátor), posuvník tmavého pole, zařízení fázového kontrastu (posuvník a objektivy), kondenzor tmavého pole (pro suché objektivy nebo olejovou imerzi), zařízení fázového kontrastu (kondenzor a objektivy) |
| Typ uživatele | profesionálové, zkušení uživatelé |
| Úroveň obtížnosti montáže a instalace | komplikované |
| Možnosti použití | laboratorní/lékařská |
| Umístění světelného zdroje | spodní |
| Metody pozorování | světlé pole |
| Pouzdro/kufřík/taška v sadě | protiprachová ochrana |
Doplňkové parametry
| Kategorie: | Mikroskopy |
|---|---|
| EAN: | 5905555019451 |
Hodnocení produktu
Buďte první, kdo napíše příspěvek k této položce.
Diskuze
Buďte první, kdo napíše příspěvek k této položce.